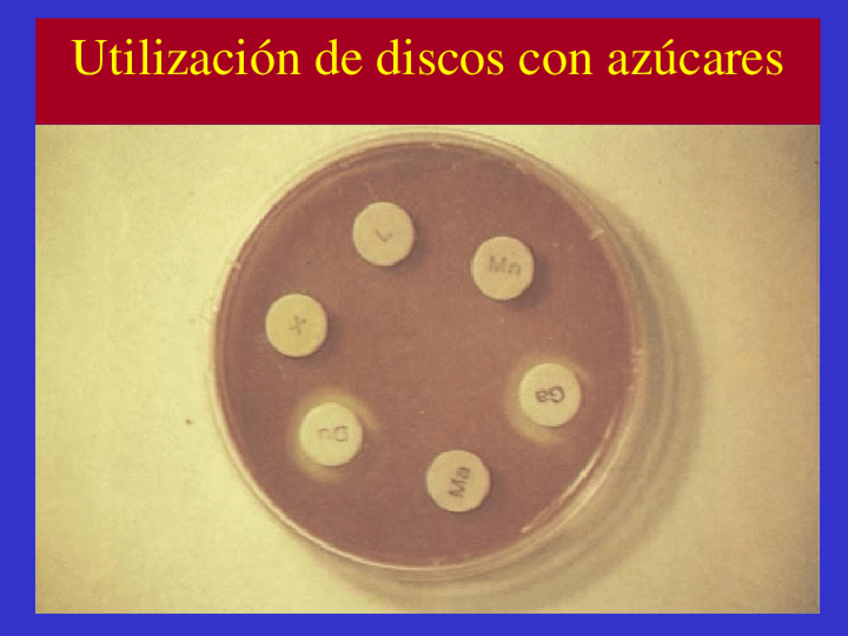

@user_5678547
203 Publicaciones
414 Interacciones
9 Seguidores
0 Siguiendo
Lista de publicaciones de user_5678547
He publicado nuevos apuntes de Gestión de Muestras Biológicas: UD3-gmb-AV-1.pdf
He publicado nuevos apuntes de Gestión de Muestras Biológicas: UD4.-MUESTRAS-BIOLOGICAS-HABITUALES-1.pdf
He publicado nuevos apuntes de Gestión de Muestras Biológicas: ud5-tecnicas-5-1.pdf
He publicado nuevos ejercicios de Técnicas de inmunodiagnóstico: ENTREGA-2-INMUNO-1.pdf
He publicado nuevos ejercicios de Técnicas de inmunodiagnóstico: EJERCICIOS-2.1Maria.pdf
He publicado nuevos ejercicios de Técnicas de inmunodiagnóstico: EJERCICIOS-INMUNO-2.pdf
He publicado nuevos practicas de Técnicas de inmunodiagnóstico: Ejercicios-inmunoUD.3.pdf
He publicado nuevos practicas de Técnicas de inmunodiagnóstico: PRACTICA-1INM.pdf
He publicado nuevos apuntes de Microbiología Clínica: Espectrometria-de-masas-5.pptx
He publicado nuevos apuntes de Microbiología Clínica: Tema-09-Antibiograma-6.pptx
He publicado nuevos apuntes de Microbiología Clínica: Tema-082-Pbmetabolismo.pptx
He publicado nuevos apuntes de Microbiología Clínica: Sistemas-de-identificacion-multipruba-y-automatizados.pptx
He publicado nuevos ejercicios de Técnicas de inmunodiagnóstico: Actividad-UD.7.pdf
He publicado nuevos ejercicios de Técnicas de inmunodiagnóstico: EJERCICIOS-UD.7.pdf
He publicado nuevos ejercicios de Técnicas de inmunodiagnóstico: TEST-TEMA-5-1.pdf
He publicado nuevos ejercicios de Técnicas de inmunodiagnóstico: INMUNO-UD.4.pdf
He publicado nuevos examenes de Técnicas de análisis hematológico: EXAMEN-HEMATO.pdf
He publicado nuevos ejercicios de Análisis Bioquímico: Diagnostico-y-seguimiento-embarazo.pdf